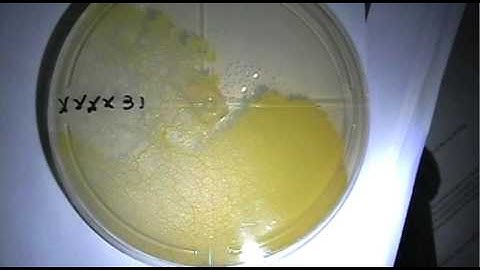
24H chrono, Phyphy style

⬇ DOWNLOAD NOW
Kalau muncul iklan pop-up, tutup lalu klik tombol kembali
Download lagu Physarum polycephalum pulsing front secara gratis hanya untuk keperluan promosi. Dukung artis favorit kamu dengan membeli musik original di iTunes atau platform resmi lainnya.
 This Pulsating Slime Mold Comes in Peace (ft. It's Okay to Be Smart) | Deep Look
This Pulsating Slime Mold Comes in Peace (ft. It's Okay to Be Smart) | Deep Look
 Slime mould solves maze: original video
Slime mould solves maze: original video
 P Polycephalum Pulsing
P Polycephalum Pulsing
 Insane Plasmodial Pulsing: How I Film Slime Mold Time Lapses on my iPhone
Insane Plasmodial Pulsing: How I Film Slime Mold Time Lapses on my iPhone
 Slime mold form a map of the Tokyo-area railway system
Slime mold form a map of the Tokyo-area railway system
24H chrono, Phyphy style
24H chrono, Phyphy style
 Genius Slime Mold Solves a Maze!
Genius Slime Mold Solves a Maze!
 Physarum polycephalum on oats
Physarum polycephalum on oats